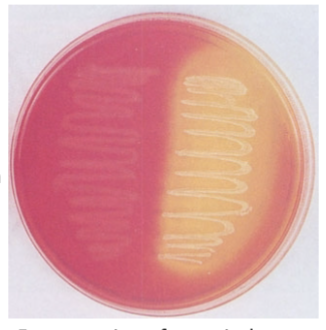
<p>Mannitol Salt Agar</p>
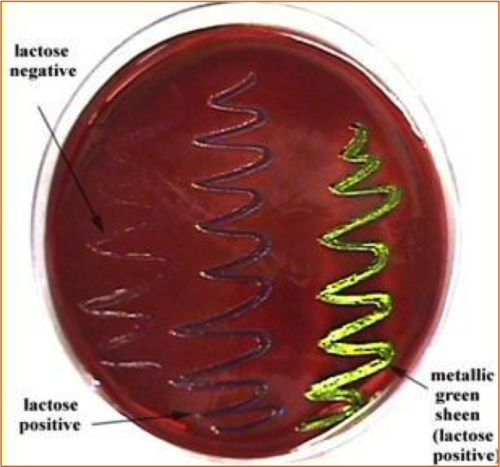
<p>EMB- Eosin Methylene Blue&nbsp;</p>

microbio lab practical 2
1/18
There's no tags or description
Looks like no tags are added yet.
Name | Mastery | Learn | Test | Matching | Spaced | Call with Kai |
|---|
No study sessions yet.
19 Terms

phenol red glucose test
to see if organism ferments glucose, positive is yellow and has bubble meaning ferments glucose and makes acid, negative is red and no bubble meaning does not ferment glucose
Phenol Red Lactose
selective for gram neg and differential based on lactose fermentation, negative is red and no fermentation, positive is yellow and ferments lactose
enzyme test- oxidase test
detects the presence of specific cytochrome oxidase, an enzyme in electron transport chain, positive is purple, negative normal color
enzyme test- catalase test
detects the presence of catalase, enzyme breaks down hydrogen peroxide to water and oxygen, positive is bubbling, negative is no bubbles
Mannitol Salt Agar
selective for halotolerant and differential for mannitol fermentation, inhibits gram neg, positive is yellow and fermenting mannitol and can grow in high salt, negative is pink and not fermenting mannitol and can’t grow in salt
EMB- Eosin Methylene Blue
slightly selective and differential of gram neg, inhibits gram positive, blue black colonies with green metallic are lactose fermenting, colorless and transparent colonies are non lactose fermenters

Novobiocin Sensitivity Test
novobiocin is antibiotic that targets the dna gyrase of bacteria and blocks atpase activity, differentiates between species of staphylococci, resistance can grow near antibiotic, nonresistant has ring

Fluid Thioglycollate test- colonies in top layer only
obligate aerobe, need oxygen

Fluid Thioglycollate test- colonies on bottom of tube
obligate anaerobe, only uses fermentation

Fluid Thioglycollate test- alot of colonies on top layer and some colonies on bottom layer
facultative anaerobe, makes atp using oxygen or fermentation when no oxygen is present

Fluid Thioglycollate test- colonies are right below top layer
microaerophilic, need low levels of dioxygen

Fluid Thioglycollate test- colonies are in top and bottom layer
aerotolerant, use fermentation to make atp and not oxygen

Bile Esculin
selective for bile tolerance and differential based on breaking down esculin, negative is normal color and can’t break down esculin, positive is black and breaks down esculin
6.5% NaCl TSB
selects for halotolerant organisms, positive has growth, negative no growth

nitrate broth- 6
ability to reduce nitrate to nitrite or n2, positive is red for nitrate to nitrite, positive is clear and has bubble for nitrate to n2, if clear after adding reagents, zinc is added, negative is red, positive is clear

Citrate Slant-
ability to use citrate as sole source of carbon, negative is green and ph dec, positive is blue and can use citrate

VP- Voges Proskauer test
ability to ferment glucose all the way, based on detection of acetoin, negative is brown, positive is red meaning acetoin is present and fermented glucose

MR- methyl red
is organism fermenting, negative is yellow meaning fermented glucose and formed low levels of end products, positive is red meaning glucose fermented to lactate, formate or acetate

SIM
differentiate organism based on h2s production, indole formation, motility, negative sulfur is normal and indole is yellow, positive sulfur is black and indole is red, positive indole means tryptophan is converted to indole by adding kovac reagent, positive sulfur means iron sulfide formed